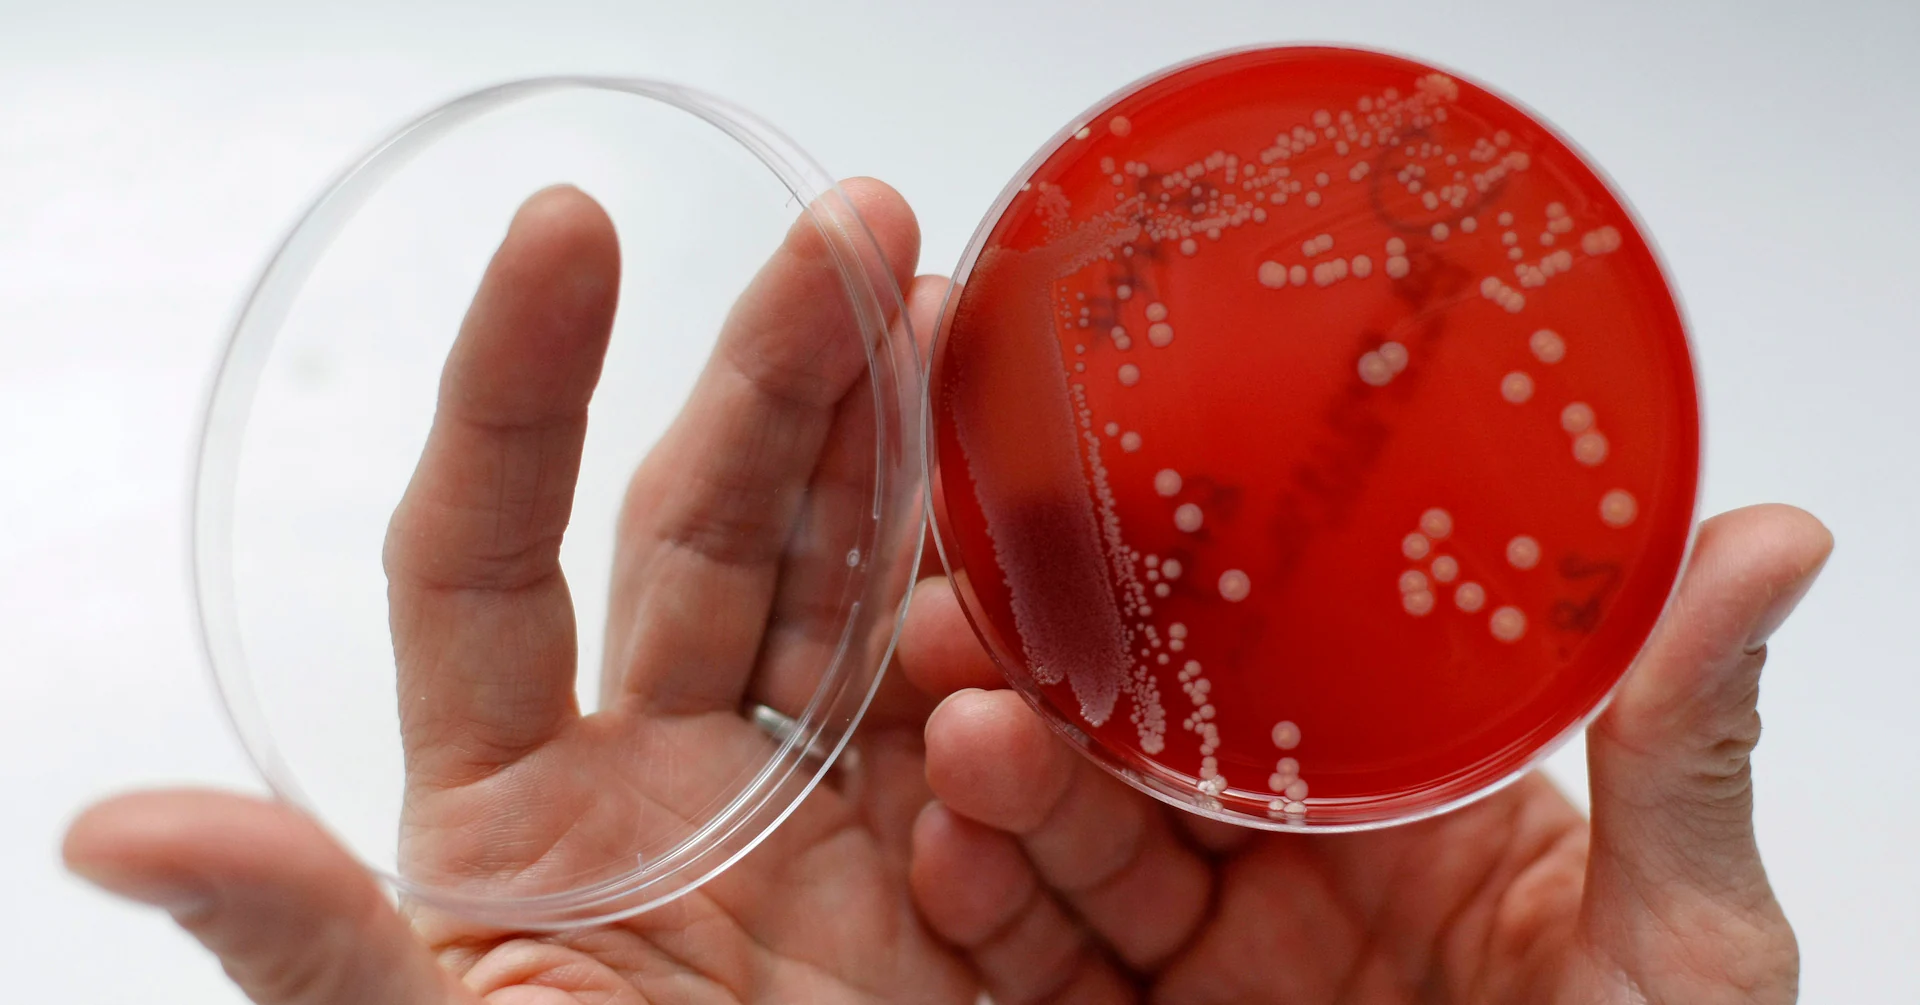
Health Rounds: Viruses may hold key to tackling deadly bacterial infection

Copyright Reuters
Oct 31 (Reuters) - Tiny viruses that only infect and kill bacteria can help treat deadly antibiotic-resistant bloodstream infections with Staphylococcus aureus, results from a mid-stage trial suggest. Researchers tested the approach in 42 patients with S. aureus bacteremia that had spread from the blood into the tissues, which they called “one of the most serious and difficult-to-treat bacterial infections.” Sign up here. At multiple time points, patients receiving the bacteriophage cocktail along with antibiotics had higher clinical success than those receiving only the antibiotics. At day 12, for example, response rates were 88% with the virus treatment and 58% for the placebo group. “These findings provide strong rationale for a Phase 3 study and signal a potential paradigm shift in how we treat antibiotic-resistant infections,” study leader Dr. Loren Miller of Harbor-UCLA Medical Center said in a statement. “High-purity, phage-based therapeutics like (this one) may one day become a new standard of care for patients facing this life-threatening condition.” NEW PATHS FOR FIGHTING YELLOW FEVER AND TICK-BORNE VIRUSES Experimental decoy molecules may be able to keep two types of deadly viruses from infecting human cells, researchers reported in two separate papers. Their discovery of how these viruses enter cells, and the subsequent development of the decoys, potentially sets the stage for new strategies to prevent and treat tick-borne encephalitis viruses, which infect the central nervous system, and the yellow fever virus, which in severe cases can cause liver failure, bleeding, and shock, the researchers said. “There are no treatments for these viral infections, so there is an urgent need for new strategies to prevent and treat these infections, which continue to cause severe disease and death in far too many cases,” Dr. Michael Diamond of WashU Medicine in St. Louis, the senior author of both papers, said in a statement. The researchers used genetic techniques, including CRISPR gene editing technology, to determine that the viruses use a family of proteins on human cell surfaces called low-density lipoprotein receptors (LDLR) as their main route of entry. These proteins were already known to be entry routes for other types of viruses. Removing these receptor proteins from the surfaces of cells blocked the viruses from infecting those cells, the researchers said. For both types of viruses, the researchers also designed “decoy” molecules. Carrying a small piece of the entry-receptor proteins, the decoys trick the viruses into latching on, thereby protecting cells from infection. The decoy molecules prevented infection in human and mouse cells in test tubes. In mice, the decoys protected against a lethal dose of yellow fever virus and also prevented the liver damage typically caused by the virus. “Our studies showing how these viruses get into cells creates opportunities to disrupt those routes, stopping viral infections from jumping animal species — both wild and domesticated — and spreading through populations of people,” Diamond said. WORKING TOWARD PREVENTION OF ANTIBIOTIC RESISTANT BIOFILMS A new discovery shows how Pseudomonas aeruginosa bacteria manage to colonize into hard-to-destroy communities, a finding that may help pave the way to new treatments, researchers say. Pseudomonas bacteria are notorious for their ability to form antibiotic-resistant biofilms that protect them from environmental stresses and help them survive for long periods. All of this information is translated into chemical signals inside the cell that guide the operation of other bacterial machinery, such as the controlled secretion of more sugars to make biofilms, the researchers said. “People have thought of pili mostly as appendages for moving around. It turns out they also act as sensors that translate force into chemical signals within bacteria, which they use to identify sugars,” senior author Gerard Wong of UCLA said in a statement. “We’re seeing how sensory information is encoded in bacteria by their appendages for the first time.” The researchers say they can envision building on these results to influence the bacteria’s behavior. “We might be able to turn the cells into more antibiotic-susceptible versions of themselves that are easier to treat,” study co-leader William Schmidt of UCLA said in a statement. (To receive the full newsletter in your inbox for free sign up here) Reporting by Nancy Lapid; Editing by Bill Berkrot Our Standards: The Thomson Reuters Trust Principles., opens new tab Nancy has been a health news reporter and editor at Reuters for more than a decade, covering important medical research advances. She is the author of our twice-a-week Reuters Health Rounds newsletter.



